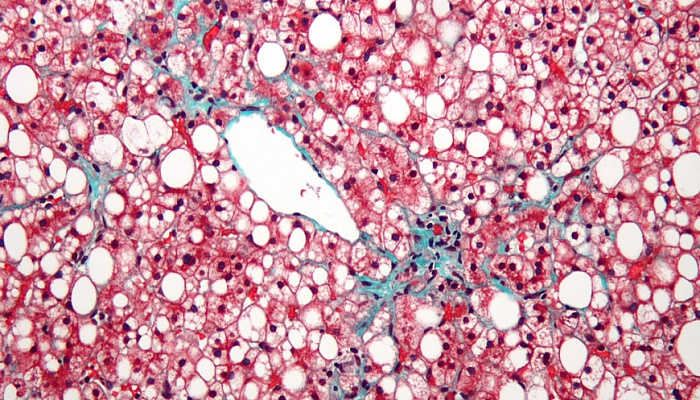

Стеатоз Печени Фото
Стеатоз Печени Фото 111 фото
Современные Душевые Дизайн Фото
Храмы Города Владимира Фото
Королла Тюнинг Фото
Рыбы Семейства Тресковых Названия И Фото
Каскад На Короткие Волосы Картинки
Фото Артистов Метод Михайлова
Фото Нагих Дам
Худеющие Отзывы Фото До И После
Фото Толстого Пледа
Сколько Ягод На Картинке